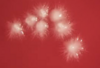
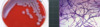

generally, how do viruses cause upper respiratory infections
viruses disrupt the stratified squamous epithelial cells that line the oral/nasopharynx
this disruption allows normal bacteria in the area to produce infections
what are four factors that can predispose you to an infection
1.) overuse of antibiotics or immunosuppressive therapy (steroids/radiation)
2.) inadequate hydration
3.) malnutrition/old age
4.) immunosuppressive diseases (cancer/HIV)
describe some features of laryngitis
-usually caused by a virus
-symptoms: hoarseness/lowering of voice
if laryngitis is bacterial, what are the two main suspects?
1.) streptococcus pyogenes
2.) diphtheria
what are 6 types of viruses that can cause laryngitis
1.) influenzae
2.) rhinoviruses
3.) coronoviruses
4.) parainfluenzae
5.) adenoviruses
6.) human metapneumonviruses
what are the four main symptoms of laryngotracheobronchitits or “croup”
1.) fever
2.) difficulty breathing (stridor)
3.) hoarseness
4.) barking cough
what are 6 types of viruses that can cause laryngotracheobronchitis (croup)
1.) parainfluenzae
2.) influenzae
3.) rhinoviruses
4.) respiratory syncytial virus
5.) adenovirus
6.) mycoplasma
what is the most common virus to cause laryngotracheobronchitis or “croup”
parainfluenzae
who are most affected by laryngotracheobronchitis or “croup”
young children under 3 years of age
who are most affected by epiglottitis
children between 2 and 6
what are the four symptoms of epiglottitis
1.) fever
2.) painful swallowing
3.) drooling
4.) respiratory obstruction
what is the most common bacteria to cause epiglottitis
haemophilus influenzae type b
which 2 types of bacteria can cause epiglottitis
staph and streps (strep. pneumo.)
young children with epiglottitis are prone to what
developing bacteremia
what are the three features of a pharyngitis or tonsillitis infection caused by arcanobacterium haemolyticum
1.) gram positive, diphtheroid rod
2.) beta-hemolytic on blood agar
3.) invades pharyngeal mucosa

what are the four features of a pharyngitis or tonsillitis infection caused by streptococcus pyogenes
1.) gram positive cocci in chains
2.) catalase negative and beta-hemolytic on blood agar
3.) invades pharyngeal mucosa
4.) produces toxins and virulence factors

what are the three features of a pharyngitis or tonsillitis infection caused by corynebacterium diphtheriae
1.) gram positive rod (Chinese letters)
2.) pseudomembrane produced by diphtheria toxin
3.) obstruction by pseudomembrane

which two mediums should be used to isolate corynebacterium diphtheriae in the case of pharyngitis and tonsillitis
1.) cystine-tellurite blood agar
2.) tinsdale medium
what is the most common bacterial cause of pharyngitis or tonsillitis
streptococcus pyogenes
which antibiotic is most commonly used to treat bacterial pharyngitis and tonsillitis caused by streptococcus pyogenes
penicillin
what are the two main consequences of untreated, strep. pyogenes pharyngitis or tonsillitis
post streptococcal sequelae -acute rheumatic fever and glomerulonephritis
what are the four main symptoms of rheumatic fever
1.) fever
2.) carditis
3.) subcutaneous nodules
4.) polyarthritis
what are the four main symptoms of acute glomerulonephritis
1.) edema
2.) hematuria
3.) hypertension
4.) proteinuria
what are the four main virulence factors of bacterial pharyngitis caused by strep. pyogenes
1.) protein F
2.) M protein
3.) enzymes
4.) exotoxins